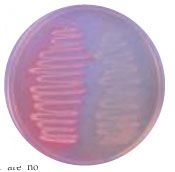

- Clinical Technology
- Adult Immunization
- Hepatology
- Pediatric Immunization
- Screening
- Psychiatry
- Allergy
- Women's Health
- Cardiology
- Pediatrics
- Dermatology
- Endocrinology
- Pain Management
- Gastroenterology
- Infectious Disease
- Obesity Medicine
- Rheumatology
- Nephrology
- Neurology
- Pulmonology
Ironic Exorcise
After drinking a cup of coffee in the lounge of St Gimmick Hospital, Dr Schmeckman accompanied one of his students, Mollie Jeanette, who was beginning her rotation through the hospital’s infectious diseases service, to the microbiology laboratory.
After drinking a cup of coffee in the lounge of St Gimmick Hospital, Dr Schmeckman accompanied one of his students, Mollie Jeanette, who was beginning her rotation through the hospital’s infectious diseases service, to the microbiology laboratory.
“Despite all the new-fangled technology that seems to be central to the lab, the technologists still can tell a lot from the culture plates,” Dr Schmeckman told Mollie. “Familiarity with the quality of growth of a particular organism, what the colony looks like on different types of agar, and what odors are produced can speed along the diagnosis.”
As they walked further into the laboratory, Dr Schmeckman picked up a Petri dish from the nearest workstation and said, “Look at this yet unused plate. It contains MacConkey agar. Culture using MacConkey agar is the classic way to distinguish lactose-fermenting from non–lactose-fermenting ‘bugs.’”
Seeing the confused look on Mollie’s face, Dr Schmeckman continued, “Distinguishing between the two helps us characterize the various gram-negative rods that we encounter. MacConkey agar is a very useful initial screening plate for culturing stool samples when looking for evidence of Salmonella. Most facultative stool flora are lactose fermenters-Escherichia coli, for example, whereas Salmonella species are non–lactose fermenters.”
Figure -A MacConkey agar plate is shown. A streak of lactose-fermenting organisms appears on the left and a streak of non–lactose-fermenting organisms appears the right.
Dr Schmeckman picked up a plate of MacConkey agar that had been inoculated the previous day. “As you can see, there are mostly red to pink colonies on the left side of this plate. These are the lactose fermenters. The colorless non-fermentors are on the right.” (Figure).
Just then, Dr Schmeckman’s cell phone rang. Mollie was surprised that the cell phone’s ringtone was “Tubular Bells” by Mike Oldfield, which is the theme song of the movie The Exorcist. Dr Schmeckman’s call was from Dr Bridget Kildare, a junior attending physician whom Dr Scheckman had trained. Dr Kildare had requested that Dr Schmeckman meet her in the emergency department (ED) to discuss a case.
“Why that ringtone?” asked Mollie, with a puzzled look.
Dr Schmeckman smiled. “I’ve always thought of infectious disease medicine-especially in regard to bacterial infections-as the branch of internal medicine that is closest to surgery because, like our surgical colleagues, we infectious disease specialists separate the patient from his or her disease process like an exorcist removes a demon. For example, while an alien organism, such as group A streptococci, resides within a person, aberrations manifest.”
On arrival at the ED, Dr Kildare told Dr Schmeckman and Mollie about the case. A 33-year-old man in whom HIV infection and pneumocystosis were diagnosed 6 years earlier had presented to the referring hospital with a fever (temperature of 40°C [104°F]) and a draining, left-sided neck mass that had persisted for 2 to 3 weeks. The patient had been nonadherent to antiretroviral therapy and had not accessed health care of any kind for several years.
Dr Schmeckman turned to Mollie and said, “Fever and a draining lateral neck mass. What do you think?”
“I think the diagnosis might be lymph node tuberculosis,” she replied. “The patient is HIV-positive and probably has a draining lymphadenitis in his neck. I’d do an acid-fast bacillus [AFB] stain on the drained fluid if it hasn’t already been performed.”
“Doggone it!” Dr Kildare interjected. “That’s the heart of the matter. The referring hospital performed at least 8 AFB stains and culture tests of the neck discharge after no organisms grew on the original culture. Every AFB stain was loaded with red snappers, but every culture-even those held for 8 weeks-was negative.”
Referring to the transfer records, Dr Kildare related additional information about the patient: “Findings from his chest radiograph were unremarkable. As of last week, his CD4+ cell count was 27/µL and his HIV RNA level was 105,000 copies/mL. As mentioned, the results of several AFB cultures of blood and stool were negative.”
Dr Schmeckman smiled thoughtfully. “We know that acid-fast bacilli are behind this illness given the consistent smear–positive specimens, even though none of the cultures grew these organisms. How ironic!” Dr Kildare and Mollie looked at each other, being puzzled by the use of the word “ironic” to describe the clinical situation.
Dr Schmeckman, sensing their dismay, continued: “No, not ironic as in ‘irony.’ I mean ironic as in ‘iron,’ specifically, the ferric form of iron. There is no doubt in my mind that incubation of the neck discharge on a culture medium containing ferric ions will yield the pathogen, which I suspect is Mycobacterium haemophilum.”
Three weeks later, when culture results were available, Dr Schmeckman’s prediction proved correct.
DiscussionM haemophilum is a mysterious “blood-loving” organism. How it is spread to humans and its natural habitat are unknown. It is aerobic and can grow in a pH range of 5.4 to 7.4. The optimal temperature for growth in vitro is 30°C to 32°C (86°F to 89.6°F), and growth occurs in approximately 2 to 3 weeks. Most important, it needs growth media that contain ferric iron compounds (specifically, ferric ammonium citrate, hemin, or hemoglobin). It strongly stains with Ziehl-Neelsen, Kinyoun, and auramine-rhodamine acid-fast staining methods. Stains will usually show characteristic short rods that are occasionally curved. The rods may appear either alone or in clumps. Before the nutritional and temperature requirements needed for culturing M haemophilum were known, many infections went undiagnosed; thus, the prevalence and clinical significance of M haemophilum infection are currently unknown.
The first documented case occurred in 1978 in a woman with Hodgkin lymphoma and chronic ulcerative skin lesions.1 Since then, many cases have been documented in immunocompromised adults, including patients with HIV/AIDS; bone marrow, heart, and kidney transplant recipients; and patients with rheumatoid arthritis, myaesthenia gravis, common variable immunodeficiency, and polycythemia vera.
The classic clinical presentation is multiple tender, ulcerating, cutaneous or subcutaneous, nodular skin lesions on extremities and on the top of joints that can subsequently evolve into draining ulcers. More rarely seen manifestations in adults include pneumonitis, sepsis,2 septic arthritis, and osteomyelitis.3 In addition, 1 documented case of epididymal abscess has been reported.4 In children, however, infection most commonly presents as chronic lymphadenitis in immunocompetent persons. Saubolle and colleagues5 observed that the cooler temperature requirements of the organism might explain why lesions frequently appear on the superficial areas of the body, which tend to be cooler than other body sites, although deep-tissue M haemophilum infections, such as pyomyositis,6 osteomyelitis, and pneumonia,5 do occur.
Currently, the most accurate way to diagnosis M haemophilum infection is not by culture but by polymerase chain reaction (PCR) assay, real-time PCR assay, or 16S ribosomal RNA gene sequencing.7-9
A goal of treatment is to reverse the immunocompromised state. This is difficult, and antituberculosis medication is needed. There are no guidelines, and case reviews suggest that different regimens are effective. Single agents such as trimethoprim/sulfamethoxazole, minocycline, erythromycin, and ciprofloxacin, as well as combinations of pyrazinamide, streptomycin, ethionamide, cycloserine, amikacin, doxycycline, clarithromycin, clofazimine, clotrimoxazole, pyridoxine, dapsone, and rifabutin have been used.10-13 No head-to-head studies comparing single-drug therapy with combination therapy exist, but because of the possibility of antibiotic resistance, combination therapy with at least 2 medications is recommended.14 It also has been suggested that patients with chronic immunosuppression should receive lifelong secondary prophylaxis.15,16
Total excision of the affected lymph node and infected tissue alone may cure localized lymphadenitis in children. However, this intervention can lead to scarring. Indeed, incision and drainage are not recommended because of possible scarring and also a higher chance of recurrence and chronic drainage from the lesion site.17,18 The role of antimicrobial therapy in children has not been well studied. Erythromycin failed to elicit a therapeutic response in 2 pediatric cases of M haemophilum infection reported in 1991,10 but clarithromycin and rifabutin therapy resulted in complete eradication of oculofacial lesions caused by M haemophilum infection in 4 months in another, more recent case report.19
Because of the increase in use of immunosuppressive therapies for malignancies, use of long-term corticosteroid therapy for various ailments, and the persistence of HIV infection in the general population, M haemophilum infection should be part of the differential diagnosis in patients with skin lesions, especially if those lesions are associated with an organism that responds to acid-fast staining techniques but does not grow on regular media used for mycobacteria. Treatment of M haemophilum infection is similar to that of other nontuberculous mycobacterial infections.Table

References:
REFERENCES
1. Armstrong KL, James RW, Dawson DJ, et al. Mycobacterium haemophilum causing perihilar or cervical lymphadenitis in healthy children. J Pediatr. 1992;121:202-205.
2. Sturenburg E, Horstkotte M, Aberle J, et al. Disseminated Mycobacterium haemophilum infection as initial manifestation of AIDS. Tuberculosis (Edinb). 2004;84:341-345.
3. Elsayed S, Read R. Mycobacterium haemophilum osteomyelitis: case report and review of the literature. BMC Infect Dis. 2006;6:70.
4. Keller M, Mak A, Thibert L, et al. Mycobacterium haemophilum epididymal abscess in a renal transplant patient. J Clin Microbiol. 2008;46:2459-2460.
5. Saubolle M, Kiehn T, White M, et al. Mycobacterium haemophilum: microbiology and expanding clinical and geographic spectra of disease in humans. Clin Microbiol Rev. 1996;9:435-447.
6. Jang EY, Lee SO, Choi SH, et al. Case of pyomyositis due to Mycobacterium haemophilum in a renal transplant patient. J Clin Microbiol. 2007;45:3847-3849.
7. Samra Z, Kaufmann L, Zeharia A, et al. Optimal detection and identification of Mycobacterium haemophilum in specimens from pediatric patients with cervical lymphadenopathy. J Clin Microbiol. 1999;37:832-834.
8. Bruijnesteijn Van Coppenraet ES, Lendeboom JA, Prins JM, et al. Real-time PCR assay using fine-needle aspirates and tissue biopsy specimens for rapid diagnosis of mycobacterial lymphadenitis in children. J Clin Microbiol. 2004; 42:2644-2650.
9. Bruijnesteijn van Coppenraet LE, Kuijper EJ, Lendeboom JA, et al. Mycobacterium haemophilum and lymphadenitis in children. Emerg Infect Dis. 2005;11:62-68.
10. Centers for Disease Control and Prevention. Epidemiologic notes and reports Mycobacterium haemophilum infections-New York City metropolitan area, 1990-1991. MMWR. 1991;40:636-637, 643.
11. Gupta I, Kocher J, Miller A, et al. Mycobacterium haemophilum osteomyelitis in an AIDS patient. N J Med. 1992;89:201-202.
12. Lederman C, Spitz JL, Scully B, et al. Mycobacterium haemophilum cellulitis in a heart transplant recipient. J Am Acad Dermatol. 1994;30(5 pt 1):804-806.
13. Shih JY, Hsueh PR, Chang YL, et al. Pyomyositis due to Mycobacterium haemophilum in a patient with polymyositis and long-term steroid use. Clin Infect Dis. 1998;26:505-507.
14. Kiehn TE, White M. Mycobacterium haemophilum: an emerging pathogen. Eur J Clin Microbiol Infect Dis. 1994;13:925-931.
15. Gouby A, Branger B, Oules R, Ramuz M. Two cases of Mycobacterium haemophilum infection in a renal-dialysis unit. J Med Microbiol. 1988;25:299-300.
16. Dawson DJ, Blacklock ZM, Kane DW. Mycobacterium haemophilum causing lymphadenitis in an otherwise healthy child. Med J Aust. 1981;2:289-290.
17. Thibert L, Lebel F, Martineau B. Two cases of Mycobacterium haemophilum infection in Canada. J Clin Microbiol. 1990;28:621-623.
18. Atkinson BA, Bocanegra R, Graybill JR. Treatment of Mycobacterium haemophilum infection in a murine model with clarithromycin, rifabutin, and ciprofloxacin. Antimicrob Agents Chemother. 1995;39:2316-2319.
19. Lindeboom JA, Kuijper EJ, Bruijnesteijn van Coppenraet ES, Prins JM. First case of an oculofacial lesion due to Mycobacterium haemophilum infection in an immunocompetent child. Oral Surg Oral Med Oral Pathol Oral Radiol Endod. 2006;101:774-776.
